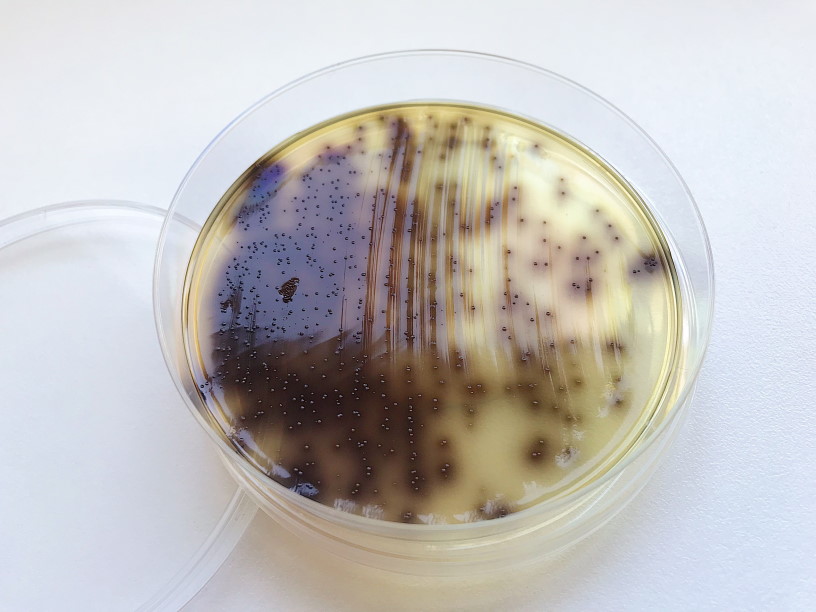

Промикробы: Темная сторона силы
А кто это у нас такой черненький вырос? Это энтерококк, знакомьтесь. Вообще энтерококки — это целое семейство бактерий. Они являются грамположительными кокками (вы же уже знаете, что это значит, верно?), часто объединяются в пары или короткие цепочки. Два вида из этого семейства являются симбиотическими организмами кишечника человека: Enterococcus faecalis и Enterococcus faecium. Энтерококки, входящие в состав нормальной микрофлоры человека, играют важную роль в обеспечении колонизационной резистентности слизистых. Другими словами, не дают еще более опасным захватчикам поселиться там, где живут сами. Однако симбиотический добрый микроорганизм тоже может перейти на сторону зла. Ничего нового, конечно, не только энтерококки так делают, но и кишечная палочка, и клебсиеллы, и многие другие. Энтерококки могут вызывать различные клинически важные инфекции: менингит, эндокардит, инфекции мочевыводящих путей, сепсис. Опасность таких попаданий в несвойственные локации усиливается еще и потому, что энтерококки имеют высокую устойчивость к антибиотикам. Но и тут ничего нового — антибиотики детям не игрушка, применяем их только после назначения врача и строго по инструкции.
⠀
Определением энтерококков как санитарно-показательных микроорганизмов пользуются при оценке санитарного состояния объектов внешней среды — питьевой воды, сточных вод. По их количеству судят о степени фекального загрязнения воды. Бактерии семейства энтерококков стали удобным маркером загрязненности благодаря тому, что хорошо выживают в окружающей среде. Кроме того, ряд исследователей считает энтерококк более чувствительным показателем фекального загрязнения, чем кишечную палочку, поскольку энтерококк практически не размножается вне организма человека или животного. То есть пока кишечная палочка активно делает детей, энтерококк просто плавает, а значит дает более достоверную информацию о своем изначальном количестве. Энтерококки используются как санитарно-показательные микроорганизмы не только для воды, но и для оценки микробиологической чистоты пищевых продуктов. Содержание энтерококков нормируется в мясе, рыбе и их продуктах.
⠀
Выделение энтерококков обычно не представляет затруднения, так как они хорошо растут на простых питательных средах. Для выделения и выращивания энтерококков используют селективно-дифференциальные среды. Одну из таких питательных сред вы можете увидеть на фото. На этой среде, изначально желто-бурой, вокруг мелких колоний энтерококков образуется черный ореол. Вокруг колоний других микроорганизмов такие зоны потемнения не образуются. А если количество энтерококков в посеве очень большое, то вся чашка становится черной, даже номер, написанный черным маркером, становится трудно прочитать. Такие чудесные свойства среды обеспечивает эскулин, который энтерококкам по зубам — они его гидролизуют, в отличие от всех своих родственников. Эскулин — это экстракт коры конского каштана. Кроме индустрии производства питательных сред для микробиологии, он также используется в фармацевтической промышленности и часто входит в состав косметических средств.
⠀
Ну, а сами маленькие любители эскулина — создания неоднозначные, как и многие другие представители микромира. Могут быть джедаями, а могут стать ситхами. Поэтому не пугайтесь, получив результат анализа, в котором указан энтерококк. Вполне может быть, что для этой части организма и в этом количестве энтерококк является вариантом нормы.
Микробы учат нас, что мир состоит не только из черного и белого, давайте различать оттенки серого.